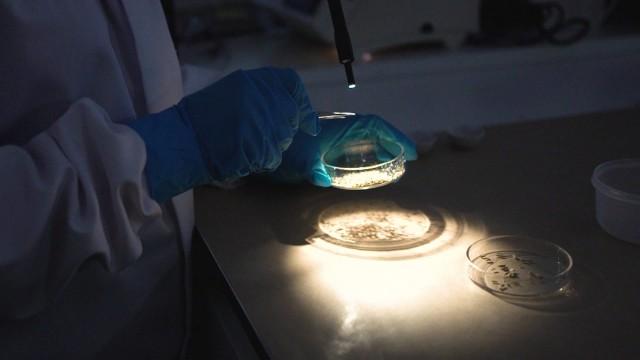
Lonely Hearts

Poisonous Liaisons
1 season • 2019 • Ended
Documentary, Crime
From scorned lovers, attempted murders, to induced paralysis Poisonous Liaisons delves into history's most notorious poisoning crimes, revealing their methods and the short and long-term effects their substances had on victims.
From scorned lovers, attempted murders, to induced paralysis Poisonous Liaisons delves into history's most notorious poisoning crimes, revealing their methods and the short and long-term effects their substances had on victims.
Episodes
People also watched
Loading comments...